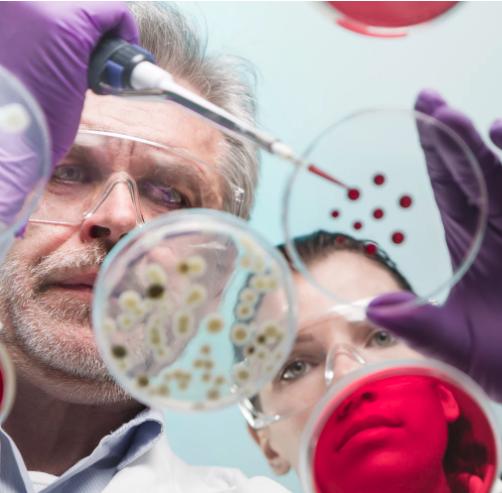
临床研究的过程是怎样的?

临床研究图片

在工作环境中研究化学元素的临床医生
图片尺寸682x1023
临床实验临床医师在实验室研究照片
图片尺寸450x300
临床研究图片
图片尺寸450x300
"国家战略性新兴产业发展规划发布:持续深化干细胞再生技术临床应用
图片尺寸1024x724
在临床实验室进行试验或研究的年轻的多种族科学家.
图片尺寸450x300
瑞德西韦三期临床试验4月底揭盲,吉利德却申请取消其"孤儿药"资格
图片尺寸1080x608
研究在实验室中的化学成分的严重临床医师照片
图片尺寸450x300
临床医学研究照片
图片尺寸450x300
中西医结合肿瘤临床研究 许玲,徐巍 编 大学教材大中专 新华书店正版
图片尺寸800x800
受试者可无理由退出临床试验|受试者|临床试验|研究者_新浪网
图片尺寸640x427
临床研究的过程是怎样的?
图片尺寸502x493
临床试验研究,药学和医学概念屏幕.照片
图片尺寸617x300
基石药业择捷美转移性非小细胞肺癌临床研究突破达到总生存期研究终点
图片尺寸640x320
科学家研究在临床实验室的测试管照片
图片尺寸450x300
学生参与早期临床与科学研究
图片尺寸1080x720
加速成果转化 载药囊泡治胸腔积液临床研究项目在南山医院启动
图片尺寸500x323
眼科医生测量青年眼压的临床研究
图片尺寸700x467
试剂年轻女性科学家手持试管与血液标本制作研究在临床实验室中的应用
图片尺寸450x300
医生测定糖尿病患者血糖水平的临床研究照片
图片尺寸450x300
sfda体外诊断试剂临床研究技术指导原则
图片尺寸601x399